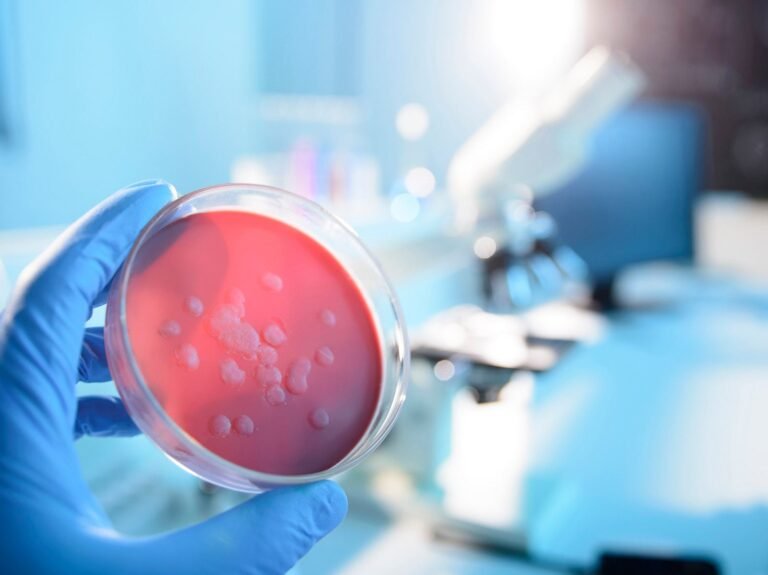
blue waffel krankheit

Blue Waffel Krankheit – Was ist wirklich dran?
Der Begriff „Blue Waffel Krankheit“ taucht seit vielen Jahren immer wieder im Internet auf. Viele Menschen stoßen dabei auf schockierende Bilder, dramatische Beschreibungen und widersprüchliche Aussagen. Deshalb entsteht schnell Unsicherheit: Ist diese Krankheit echt oder nur ein Mythos?
👉 Kurzantwort (Featured Snippet):
Die Blue Waffel Krankheit ist kein medizinisch anerkanntes Krankheitsbild. Sie gilt als Internet-Mythos, bei dem Symptome und Ursachen realer Infektionen falsch dargestellt oder stark übertrieben wurden.
Trotzdem ist das Thema wichtig. Denn viele der beschriebenen Symptome können tatsächlich auf echte Erkrankungen hinweisen. Deshalb schauen wir uns alles genau und verständlich an.
Überblick zur Blue Waffel Krankheit
| Kategorie | Details |
| Name | Blue Waffel Krankheit |
| Medizinischer Status | Nicht anerkannt |
| Ursprung | Internet (ca. 2010) |
| Betroffene | Angeblich Frauen |
| Hauptthema | Vaginale Infektion (behauptet) |
| Realität | Mythos / Fake |
| Verwechslungsgefahr | Vaginitis, Pilzinfektion, STDs |
Ursprung und Bedeutung der Blue Waffel Krankheit
Der Begriff „Blue Waffle“ entstand etwa um das Jahr 2010 im Internet. Besonders in Foren und sozialen Medien verbreiteten sich schockierende Bilder und Geschichten sehr schnell. Viele Nutzer glaubten, es handle sich um eine echte, gefährliche Krankheit.
Der Name selbst ist irreführend. „Blue“ steht für eine angebliche blaue Verfärbung, während „Waffle“ umgangssprachlich für den weiblichen Intimbereich verwendet wird.
Mit der Zeit entwickelte sich daraus ein klassischer Internet-Hoax. Das bedeutet: Eine erfundene Geschichte wird so oft geteilt, dass viele Menschen sie für real halten.
Angebliche Symptome der Blue Waffel Krankheit
Im Internet werden zahlreiche Symptome beschrieben, die oft Angst auslösen. Diese Anzeichen wirken realistisch, sind aber nicht spezifisch für eine eigene Krankheit.
Zu den häufig genannten Symptomen gehören:
- Farbveränderung von rot zu blau oder violett
- Starker Juckreiz im Intimbereich
- Schmerzen und Brennen
- Übel riechender Ausfluss
- Schwellungen und Entzündungen
Diese Symptome werden oft als fortschreitend beschrieben. Das bedeutet, sie sollen sich ohne Behandlung immer weiter verschlimmern.
👉 Wichtig: Diese Beschwerden sind nicht erfunden, aber sie gehören zu anderen, echten Erkrankungen.
Angebliche Ursachen der Blue Waffel Krankheit
Auch die Ursachen, die im Internet genannt werden, orientieren sich an realen medizinischen Faktoren.
Zu den häufig beschriebenen Ursachen zählen:
- Ungeschützter Geschlechtsverkehr
- Häufig wechselnde Sexualpartner
- Schlechte Intimhygiene
- Bakterien oder Pilze
- Enge Kleidung
- Geschwächtes Immunsystem
Diese Faktoren können tatsächlich das Risiko für Infektionen erhöhen. Trotzdem gilt:
👉 Sie führen nicht zu einer eigenen Krankheit namens Blue Waffel.
Wie bekommt man die Blue Waffel Krankheit laut Internet?
Viele Webseiten beschreiben detailliert, wie sich die Krankheit angeblich verbreitet. Dabei werden typische Übertragungswege genannt:
- Ungeschützter sexueller Kontakt
- Kontakt mit Körperflüssigkeiten
- Gemeinsame Nutzung von Sexspielzeug
- Direkter Hautkontakt im Intimbereich
Diese Beschreibungen ähneln stark echten sexuell übertragbaren Krankheiten. Genau deshalb wirkt das Ganze für viele Menschen glaubwürdig.
👉 Doch: Es gibt keine wissenschaftlichen Beweise für diese Übertragung in Bezug auf eine „Blue Waffel Krankheit“.
Warum die Blue Waffel Krankheit ein Mythos ist
Der wichtigste Punkt ist eindeutig:
👉 Es gibt keine medizinischen Belege für diese Krankheit.
- Kein Arzt hat sie offiziell diagnostiziert
- Keine Studien belegen ihre Existenz
- Keine medizinischen Fachbücher führen sie auf
Die Geschichte verbreitete sich vor allem durch:
- Schockierende Bilder
- Falschinformationen
- Virale Beiträge im Internet
Viele Bilder, die im Zusammenhang mit der Krankheit gezeigt werden, sind manipuliert oder zeigen andere medizinische Zustände.
Welche echten Krankheiten dahinterstecken können
Die beschriebenen Symptome passen jedoch zu echten Erkrankungen. Deshalb ist es wichtig, diese korrekt zu verstehen.
Mögliche echte Ursachen sind:
- Vaginitis (Scheidenentzündung)
- Pilzinfektionen (Candida)
- Bakterielle Vaginose
- Sexuell übertragbare Krankheiten (z. B. Chlamydien)
Diese Erkrankungen können:
- Juckreiz verursachen
- Schmerzen auslösen
- Ausfluss hervorrufen
👉 Aber: Keine dieser Krankheiten führt zu einer echten „blauen“ Verfärbung, wie im Mythos beschrieben.
Warum sich der Mythos so stark verbreitet hat
Die Blue Waffel Krankheits ist ein typisches Beispiel für Internet-Desinformation.
Die Gründe für die schnelle Verbreitung sind:
- Schockeffekt durch Bilder
- Neugier und Angst
- Fehlende Aufklärung über Sexualgesundheit
- Virale Inhalte in sozialen Medien
Viele Menschen suchen nach Antworten und stoßen dabei auf falsche Informationen. Dadurch verbreitet sich der Mythos immer weiter.
Ist die Blue Waffel Krankheits gefährlich?
Die Krankheit selbst ist nicht gefährlich, weil sie nicht existiert. Trotzdem kann das Thema indirekt problematisch sein.
Warum?
- Menschen könnten echte Symptome ignorieren
- Falsche Informationen führen zu Angst
- Betroffene schämen sich und suchen keine Hilfe
👉 Deshalb ist Aufklärung besonders wichtig.
Was man stattdessen beachten sollte
Auch wenn die Blue Waffel Krankheits ein Mythos ist, sind die zugrunde liegenden Themen sehr real.
👉 Achte auf deine Gesundheit:
- Verwende Schutz beim Geschlechtsverkehr
- Achte auf gute Intimhygiene
- Teile keine intimen Gegenstände
- Gehe regelmäßig zu Vorsorgeuntersuchungen
- Suche bei Beschwerden frühzeitig einen Arzt auf
Frühe Behandlung verhindert Komplikationen und sorgt für Sicherheit.
Medizinischer Hinweis (Disclaimer)
Dieser Artikel dient ausschließlich der allgemeinen Information und ersetzt keine medizinische Beratung. Bei Beschwerden oder Unsicherheiten solltest du immer einen Arzt oder eine medizinische Fachperson konsultieren.
Quellen und vertrauenswürdige Informationen
- Weltgesundheitsorganisation (WHO)
- Centers for Disease Control and Prevention (CDC)
- Gesundheitsportale zu Vaginalinfektionen
- Medizinische Fachliteratur zu Infektionskrankheiten
Mehr lesen: Andreas Ehn Vermögen 2026 – Biografie, Karriere, Investitionen & Net Worth
Häufig gestellte Fragen zur Blue Waffel Krankheit
Die Blue Waffel Krankheit ist ein Internet-Mythos und keine echte medizinische Diagnose.
Nein, es existieren keine bestätigten medizinischen Fälle.
Weil schockierende Bilder und virale Inhalte im Internet weit verbreitet sind.
Ja, aber sie gehören zu anderen Erkrankungen wie Infektionen oder Entzündungen.
Da die Krankheit nicht existiert, ist kein spezifischer Schutz nötig. Allgemeine Hygiene und Schutz beim Sex sind jedoch wichtig.
Ja, unbedingt. Beschwerden sollten immer medizinisch abgeklärt werden.
Fazit: Blue Waffel Krankheit einfach erklärt
Die Blue Waffel Krankheit ist kein echtes medizinisches Problem, sondern ein weit verbreiteter Internet-Mythos. Zwar werden Symptome und Ursachen beschrieben, doch diese stammen aus realen Erkrankungen und wurden falsch dargestellt oder übertrieben.
👉 Wichtig ist:
- Die Krankheit existiert nicht
- Die Symptome können jedoch real sein
- Eine ärztliche Abklärung ist immer sinnvoll
Wer sich informiert und auf verlässliche Quellen achtet, kann Fehlinformationen vermeiden und die eigene Gesundheit besser schützen.